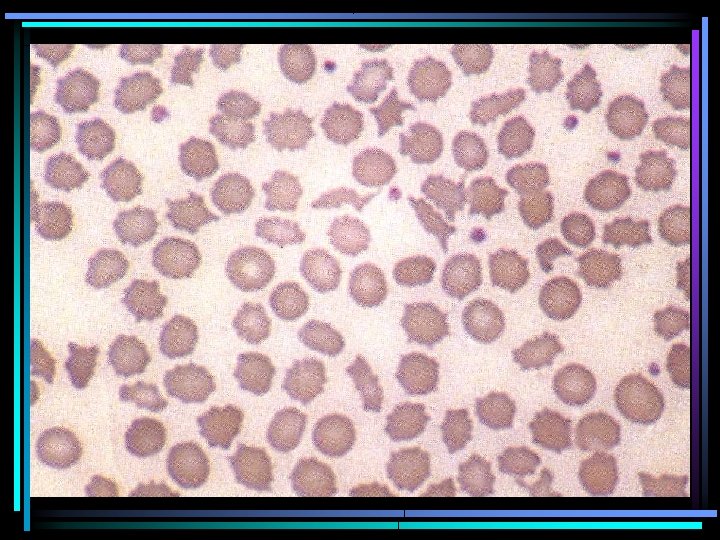
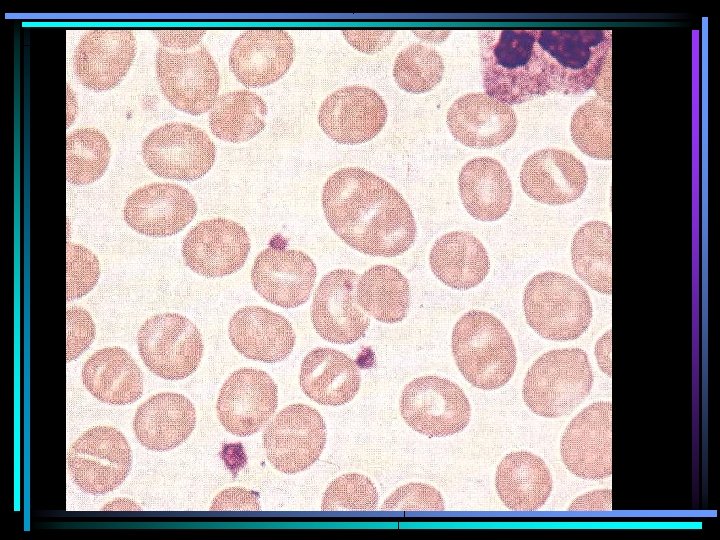
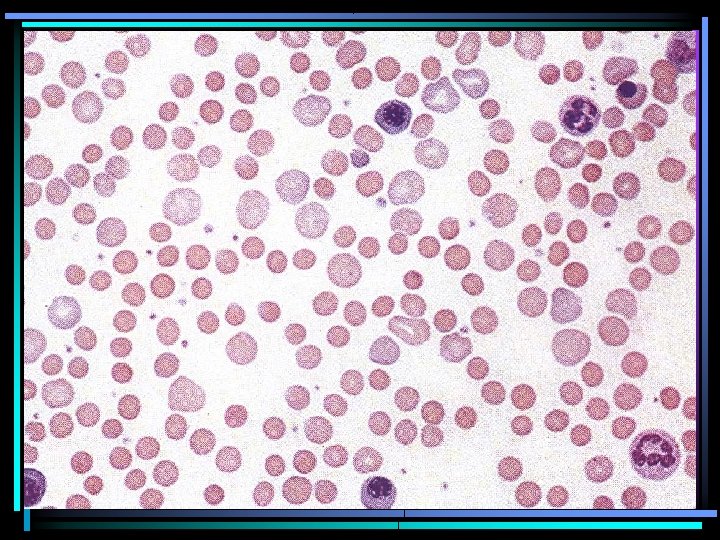
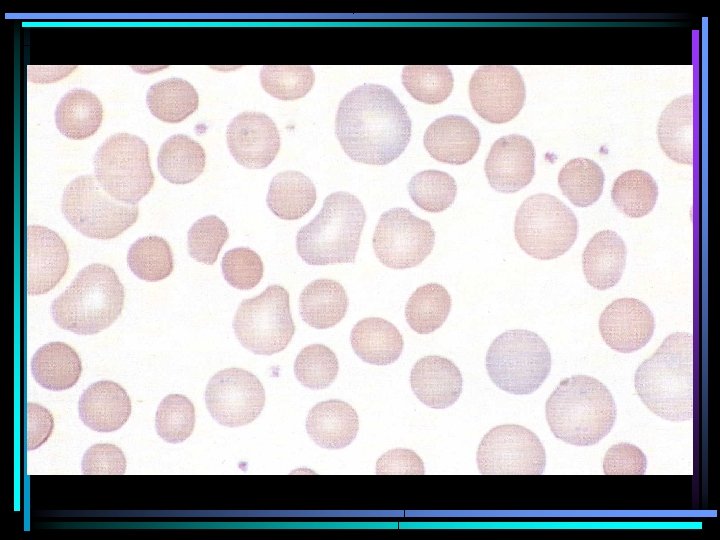
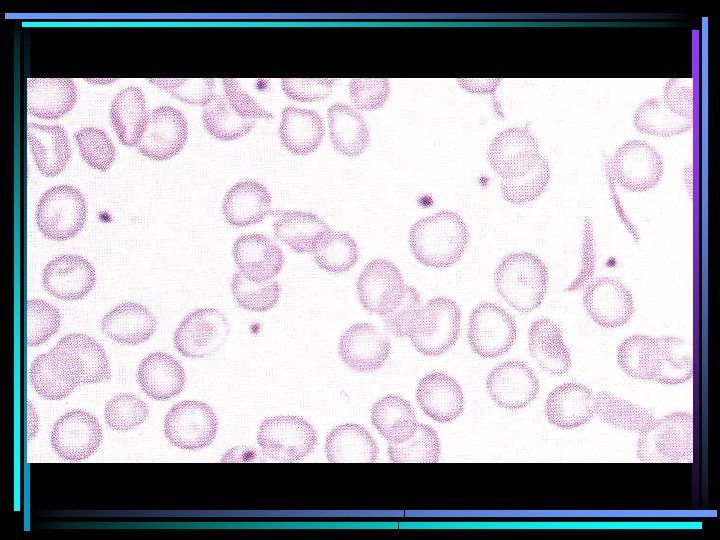
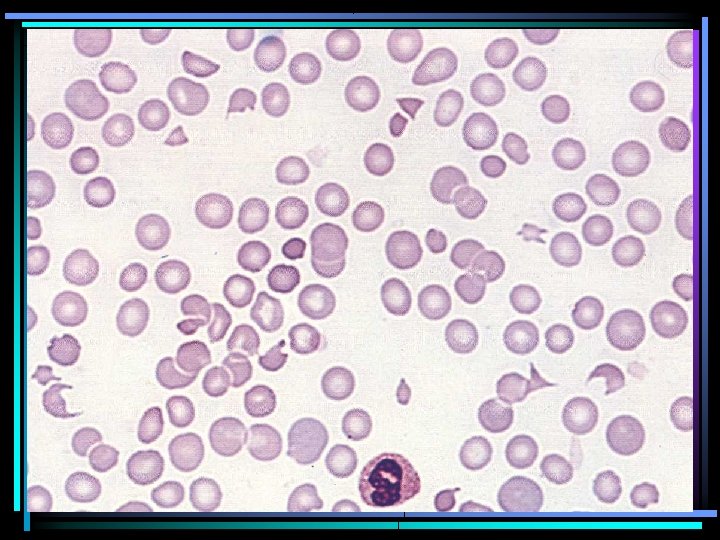
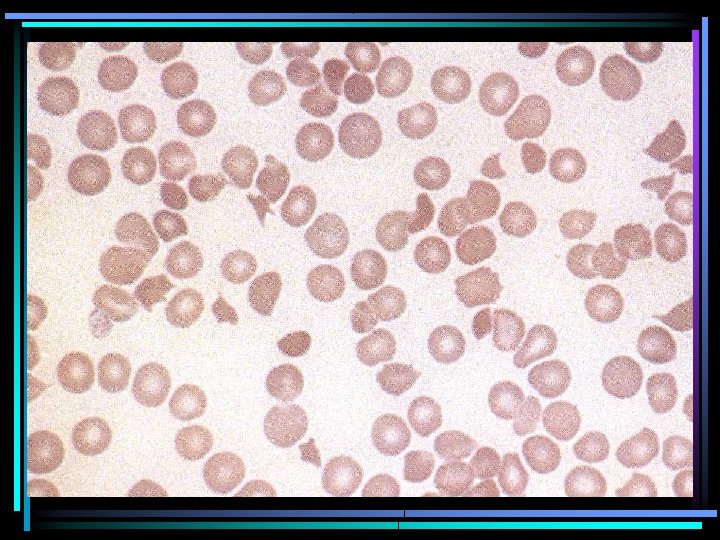
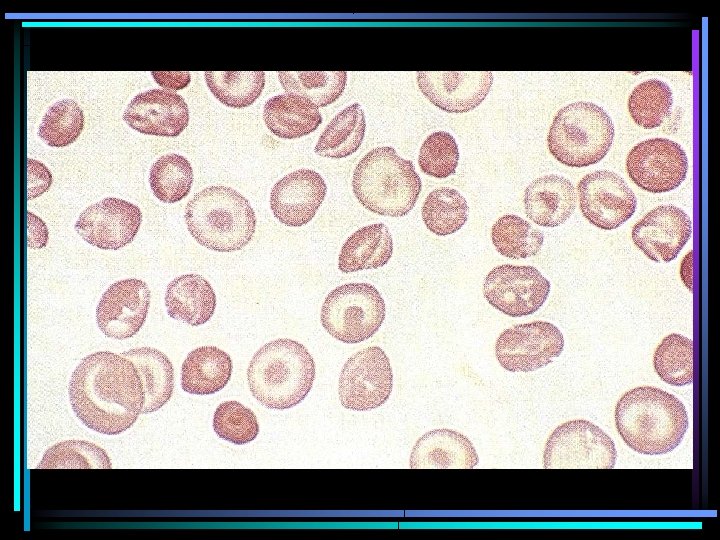
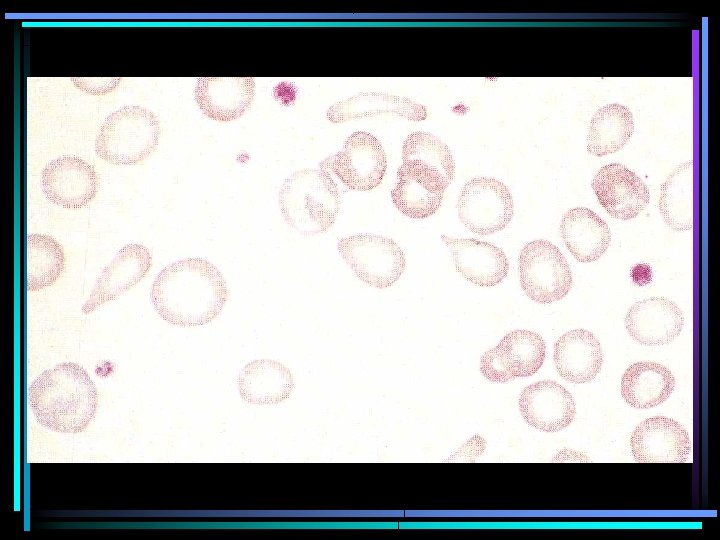
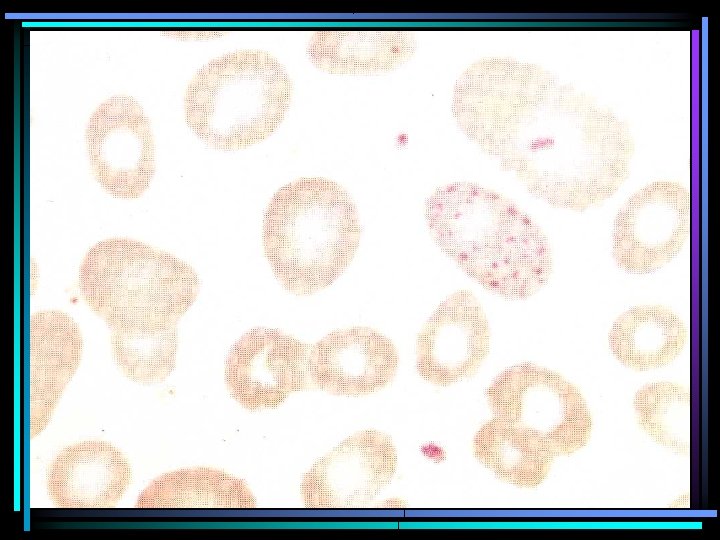
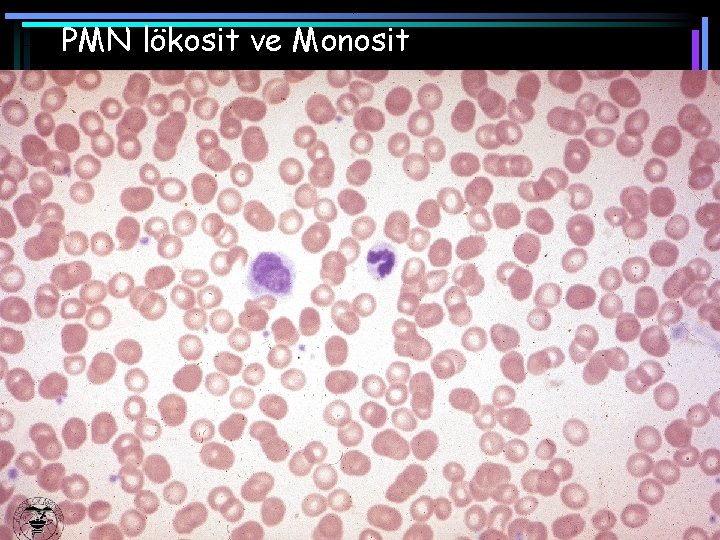
PMN lökosit ve Monosit
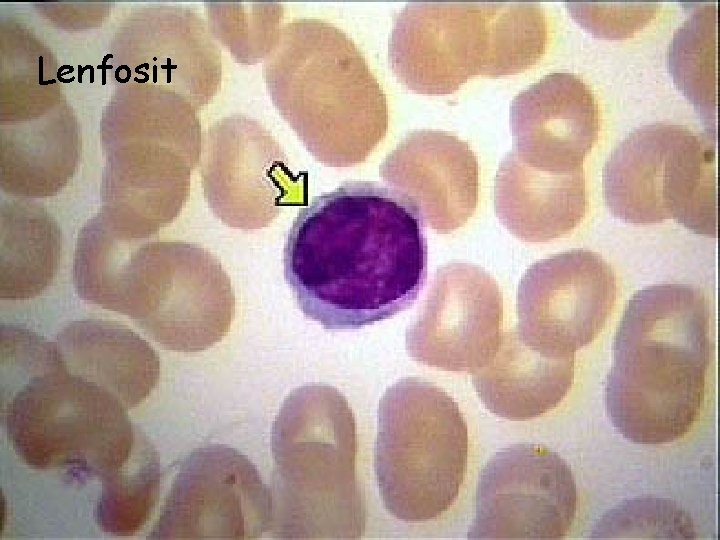
Lenfosit
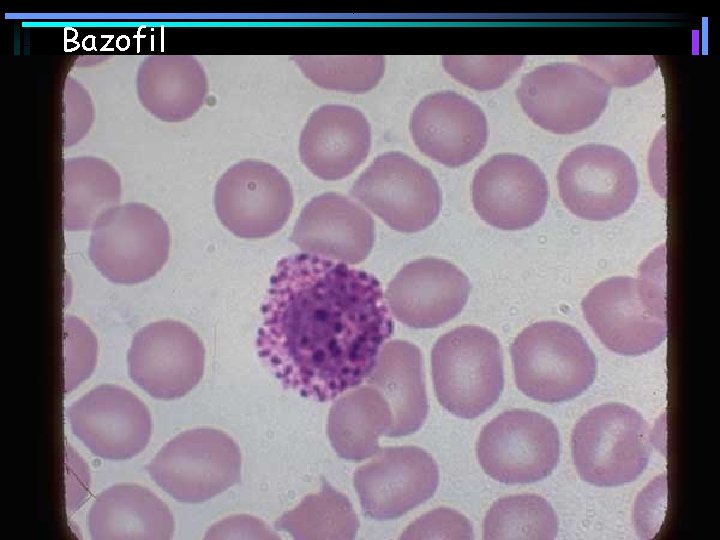
Bazofil
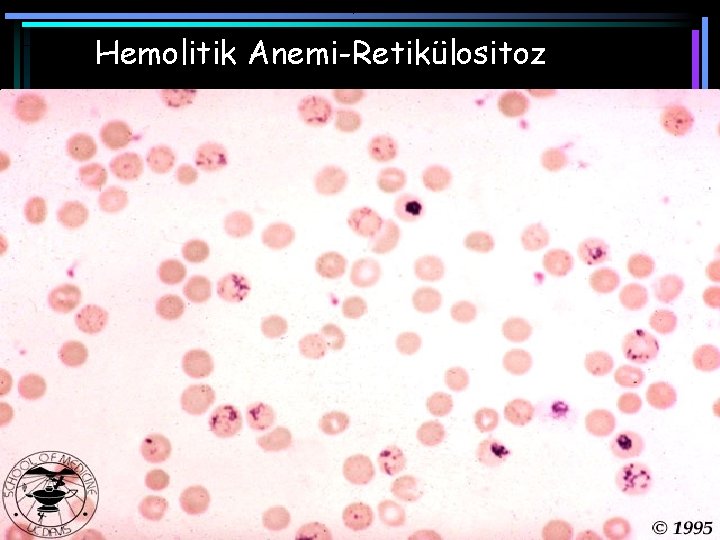
Hemolitik Anemi-Retikülositoz
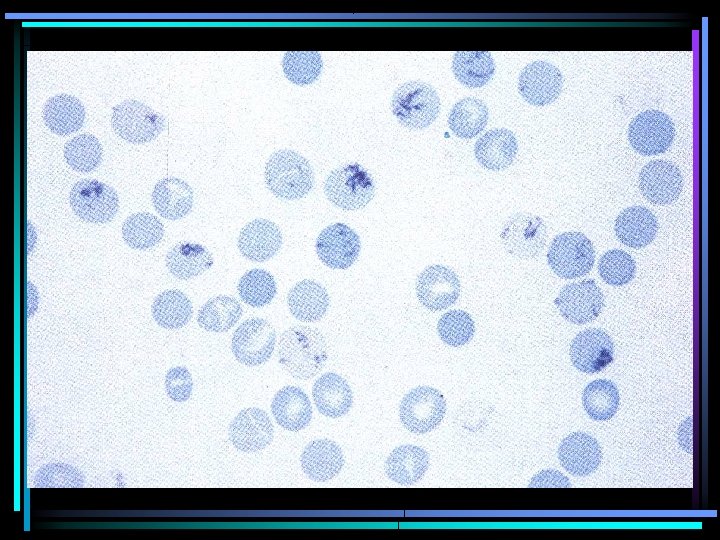

Periferik Yayma Dr Cengiz Canpolat Pediatrik HematolojiOnkoloji Wright







































































































- Slides: 103

Periferik Yayma Dr. Cengiz Canpolat Pediatrik Hematoloji-Onkoloji









Wright boyası • Metakromatik boya • Metanol çözücü içinde eozinle metilen mavisinin karışımından elde ediliyor. • p. H 6. 4 -6. 7 olmalı

Asidik Boya (pembe boyanma) • Yetersiz boyanma zamanı • Uzun süreli yıkama • Eski boya – Boyama zamanını uzat – Boyanın p. H’ini kontrol et – Yıkama zamanını kısalt

Bazik boyanma (koyu renkli mavi mor boyanma) • • Çok kalın yayma Uzun süreli boyama Yetersiz yıkama Boya p. H’inin alkalin olması – p. H’İ kontrol et – Boya süresini kısalt

Düzgün saha

Çok ince

Çok kalın

• Eritrosit çapının normalden küçük olmasına mikrositoz, büyük olmasına makrositoz adı verilir. • Anizositoz, eritrositlerin çapları arasında belirgin farklılık bulunmasıdır. • Hipokromi, eritrositin ortasındaki soluk boyalı alanın çapının büyümesidir. Hemoglobin sentezinin azalması sonucu meydana gelir. • Polikromazi, artık RNA içeren genç eritrositlerin normalden daha büyük olarak, pembe-gri veya pembe-mavi boyanmasıdır. Supravital boyalarla boyandığında bunların retikülosit olduğu görülür. • Poikilositoz, eritrositlerin şekillerinin birbirinden belirgin olarak farklılık göstermesidir.

ANİZOSİTOZ

POİKİLOSİTOZ

ANİZOSİTOZ, POİKİLOSİTOZ, HİPOKROMİ, MİKROSİTOZ

Hemolitik Anemi-Polikromazi

POLİKROMAZİ

BURR CELL (EKİNOSİT) • Eritrositlerde kısa, birbirine eşit uzaklıkta dikensi çıkıntılar vardır. – Üremi – Piruvat kinaz eksikliği – Eritrosit içi potasyum düzeyi düşüklüğü – Banka kanı transfüzyonundan hemen sonra – Mide kanseri veya peptik ülser kanaması

AKANTOSİT • Eritrositlerde değişik boylarda ve pozisyonda irregüler dikensi çıkıntılar vardır. – Abetalipoproteinemi – Alkolik karaciğer hastalığı – Splenektomi sonrası – Malabsorbsiyon


STOMATOSİT • Eritrositler bikonkav yapılarını kaybedip, tek yönlü konkav hale gelip, sığ bir sahana benzer. Periferik kanda ağıza benzer şekilde görülürler. – Herediter sferositoz – Herediter stomatositoz – Alkolizm, siroz, obstrüktif karaciğer hastalığı – Eritrosit sodyum pompası defekti

SFEROSİT • Eritrositler bikonkav yapılarını kaybedip küre şeklini almıştır. Yoğun hemoglobin içeriği bulunur. – Herediter sferositoz – İmmun hemolitik anemi – Transfüzyon sonrası – Su dilüsyonuna bağlı hemoliz – Fragmantasyon hemolizi

Herediter Sferositoz Vs Normal

ELİPTOSİT • Oval – uzamış eritrositler görülür. – Herediter eliptositoz – Thalassemia – Demir eksikliği – Myelofitizik anemi – Megaloblastik anemi


SİCKLE CELL (ORAK HÜCRE) • Polimerize hemoglobin S içerene eritrositlerde bipolar dikensi çıkıntılar vardır. – Orak hücre hastalıkları (SS, S-taşıyıcılığı, SC, SD, S-thalassemia vb) – Hemoglobin C-Harlem – Hemoglobin Memphis/S

ŞİSTOSİT • Eritrositler genellikle yarım disk şeklinde görülür, küçük, irregüler eritrosit fragmantları vardır. – Mikroanjiopatik hemolitik anemi (TTP, HÜS, DİC, vaskülit, glomerülonefrit vb) – Kalp kapağı hemolizi (prostetik veya patolojik kapaklar) – Ciddi yanıklar – Yürüme hemoglobinürisi

TARGET CELL (HEDEF HÜCRE) • Eritrositler çan şeklini almıştır. Periferik yaymada hedef tahtası gibi görülürler. – Obstrüktif karaciğer hastalığı – Hemoglobin (S, C) – Thalassemia – Demir eksikliği – Splenektomi sonrası – LCAT eksikliği

DAKROSİT (TEAR DROP CELL) • Eritrositler bir uçlarından çekilmiş gibidir. Gözyaşına benzer şekildedir. – Myelofibrozis ve myeloid metaplazi – Myelofitizik anemi – Thalassemia

HOWELL-JOLLY CİSİMCİĞİ • Nükleer materyal artığıdır. Retikülosit ve eritrositlerde yoğun, mavi yuvarlak granül olarak görülür. – Postsplenektomi – Megaloblastik anemi – Hiposplenizm


CABOT HALKASI • Anormal mitoz sonucu retikülositlerde görülen, bazen de katlanıp sekiz rakamı şeklini alan halkadır. – Megaloblastik anemilerde görülür


BASOFİLİK NOKTALANMA • Ribozomların patolojik presipitasyonu sonucu ortaya çıkar. Retikülositlerde dağınık mavi granülasyon görülür. – Kurşun intoksikasyonu – Thalassemiada görülür

HEINZ BODY • Eritrosit ve retikülositlerde denatüre hemoglobinler oluşturur. Supravital boyalarla görünür hale gelirler. – G-6 -PD eksikliği – Thalassemialar – Unstabil hemoglobin hastalıkları – Hemoglobin C hastalığı

PMN lökosit ve Monosit

Polimorfonükleer lökosit

Lenfosit

Lenfosit

Büyük Lenfosit
Lenfosit

Reaktif Lenfosit

Reaktif Lenfosit

Monosit

Eozinofil

Bazofil
Bazofil

Demir Eksikliği Anemisi

Β-talassemi minör
Hemolitik Anemi-Retikülositoz

Normoblast

Orak Hücreli Anemi

Β-talassemi majör

Heinz Cisimcikleri

Fragmente Eritrosit

Megaloblastik Anemi

Megaloblastik Anemi

Trombosit

Dev Trombosit

Megakaryosit



BASOFİLİK ERİTROBLAST

BASOFİLİK ERİTROBLAST POLİKROMATOFİLİK ERİTROBLAST

BASOFİLİK ERİTROBLAST POLİKROMATOFİLİK ERİTROBLAST ORTOKROMİK ERİTROBLAST

MYELOBLAST

MYELOBLAST PROMYELOSİT

MYELOSİT PROMYELOSİT

MYELOSİT METAMYELOSİT

ÇOMAK MYELOSİT METAMYELOSİT


LENFOBLAST

ALL-L 1

ALL-L 1

ALL-L 2

ALL-L 3

ALL Kemik İliği

AML-M 3

PROLENFOSİT

Megakaryosit

